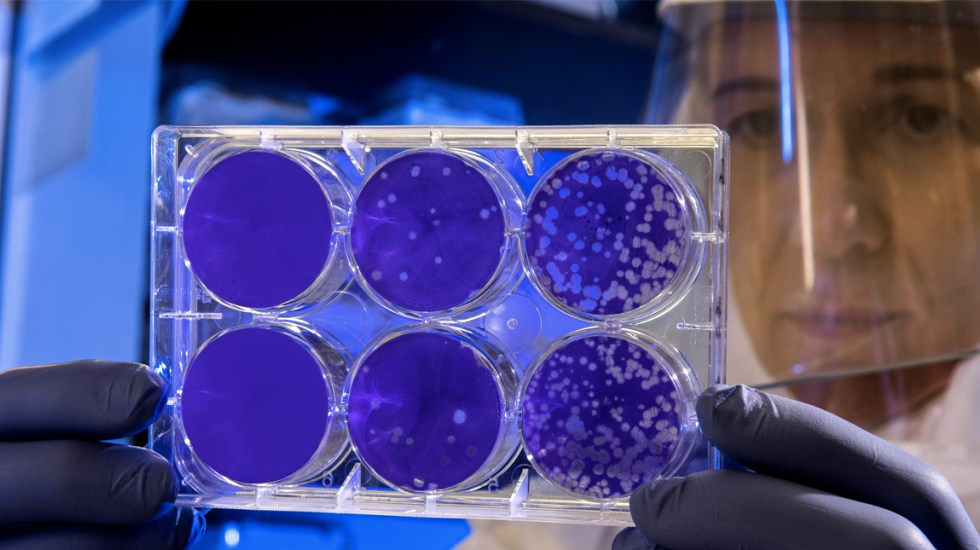

Posible portador de coronavirus en Reynosa viajó a Wuhan, China; Tamaulipas activa protocolos
El Gobierno de Tamaulipas, a través de la Secretaría de Salud estatal, informó sobre su visita y toma de muestras de un paciente masculino con enfermedad respiratoria, el cual tiene como antecedente la visita a la ciudad china de Wuhan, Hubei, donde circula una nueva cepa de coronavirus.
La titular de la dependencia, Gloria Molina Gamboa, dio a conocer que luego de la notificación del área de urgencias del ISSSTE en Reynosa, se dio parte a la Dirección General de Epidemiologia para solicitar el diagnóstico para identificación de virus respiratorio.
Indicó que el sujeto de 57 años, de origen asiático, con residencia en Reynosa, presenta tos seca y rinorrea (escurrimiento nasal); actualmente, no presenta fiebre y se mantiene en constante comunicación con los servicios de salud.
También dijo que, como parte del protocolo, la dependencia instaló en la ciudad fronteriza una red hospitalaria para la detección temprana de neumonías y síndromes de insuficiencia respiratoria severa, sin que se hayan presentado casos hasta el momento.
Molina Gamboa señaló que el pasado 25 de diciembre pasado, el paciente viajó a China, saliendo de Reynosa a la Ciudad de México, con escala en Tijuana, posteriormente llegada a Beijing y el mismo día a la ciudad de Wuhan, Hubei.
El hombre convivió con cuatro familiares y refirió que no convivió con enfermos, se comunica diariamente con ellos y actualmente se reportan sanos, además no tuvo convivencia con animales y visitó algunas ciudades cercanas.
Este paciente regresó el 10 de enero, saliendo de la ciudad de Wuhan, Hubei, con rumbo a Beijing, con escala en Tijuana, Ciudad de México y regresó a Reynosa el día 11 de enero.
Para el lunes 13 de enero inició con tos, el jueves 16 empezó con flujo nasal, no dolor de pecho, no dolor de garganta, vive solo y no convive con personas enfermas.
Molina Gamboa precisó que, tanto al paciente como a su acompañante, se les tomó una muestra de faringe y orofaringe, las cuales enviaron este miércoles al Instituto de Diagnóstico y Referencia Epidemiológicos (INDRE) para su diagnóstico, el cual se espera no tarde más de 72 horas.
La funcionaria dijo que el tratamiento es a base de oseltamivir, así como aislamiento social por cinco días, y señaló que se programó una visita a su centro de trabajo para realizar una búsqueda activa de contactos y casos sospechosos.
Comparte esta noticia